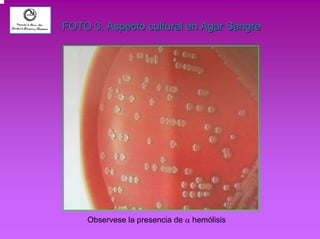
FOTO 3. Aspecto cultural en Agar Sangre 
Observese la presencia de α hemólisis
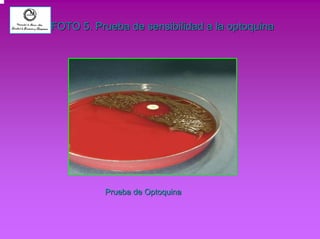
FOTO 5. Prueba de sensibilidad a la optoquina 
Prueba de Optoquina
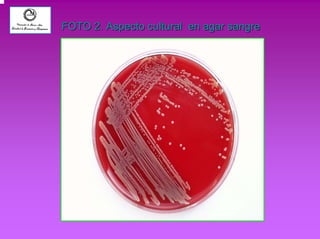
FOTO 2. Aspecto cultural en agar sangre
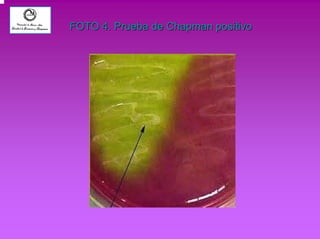
FOTO 4. Prueba de Chapman positivo
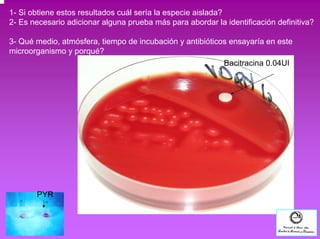
1- Si obtiene estos resultados cuál sería la especie aislada? 
2- Es necesario adicionar alguna prueba más para abordar la identificación definitiva? 
3- Qué medio, atmósfera, tiempo de incubación y antibióticos ensayaría en este 
microorganismo y porqué? 
PYR 
Bacitracina 0.04UI
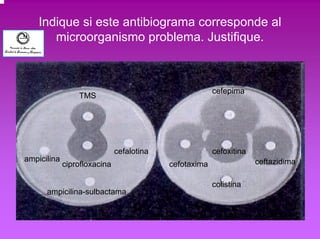
Indique si este antibiograma corresponde al 
microorganismo problema. Justifique. 
ampicilina 
cefalotina cefoxitina 
TMS 
ciprofloxacina 
ampicilina-sulbactama 
colistina 
ceftazidima 
cefepima 
cefotaxima
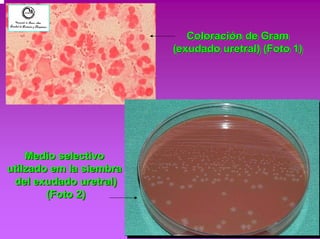
Coloración de Gram 
(exudado uretral) (Foto 1) 
Medio selectivo 
utilzado em la siembra 
del exudado uretral) 
(Foto 2)

1. El documento presenta el caso de un paciente masculino de 30 años con expectoración purulenta y fiebre que acude a consulta. Se envía una muestra de esputo para cultivo que arroja abundantes cocos gram positivos en cadenas.
2. Se describen dos problemas clínicos adicionales relacionados con infecciones nosocomiales y el control de donantes para un trasplante renal.
3. Se formulan preguntas sobre la identificación y tratamiento de posibles agentes infecciosos a partir de los resultados provistos.